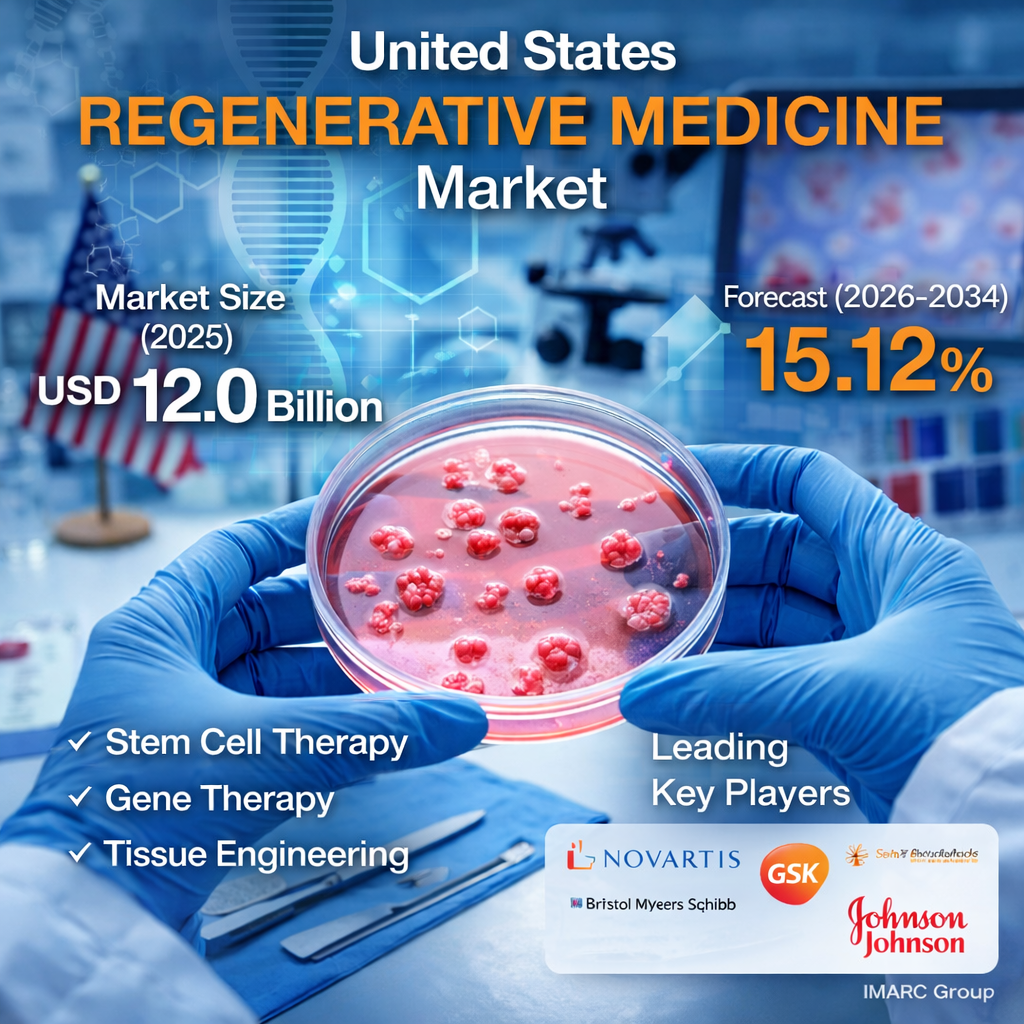

United States Regenerative Medicine Market to Reach USD 45.3 Billion by 2034, Driven by Stem Cell Advances and Personalized Therapy Demand
The United States Regenerative Medicine Market reached USD 12.0 Billion in 2025 and is projected to reach USD 45.3 Billion by 2034, exhibiting a CAGR of 15.12% during 2026-2034. IMARC states that growth is being supported by increasing demand for innovative therapeutic solutions, advancements in stem cell research, a rising geriatric population, a favorable regulatory landscape, a stronger focus on precision medicine, collaborative partnerships, and substantial financial support.
For businesses planning investment, partnerships, or commercialization strategies in 2026, the United States Regenerative Medicine Market is becoming increasingly strategic. Demand is being shaped by the need to repair or restore damaged tissues and organs, along with broader interest in therapies that may offer alternatives to conventional chronic disease management. This planning relevance for 2026 is an inference based on the IMARC forecast period and trend discussion.
Study Assumptions and Market Scope
IMARC uses 2025 as the base year, with 2020-2025 as the historical period and 2026-2034 as the forecast period. The report is presented in Billion USD and segments the market by type, application, end user, and region.
Key Market Takeaways
The United States Regenerative Medicine Market is being shaped by the increasing prevalence of chronic and degenerative disorders, including cardiovascular diseases, diabetes, and orthopedic conditions. IMARC also notes that regenerative medicine is gaining traction because it may provide more targeted and potentially curative approaches than traditional treatment pathways.
IMARC highlights that advances in stem cell research, tissue engineering, and three-dimensional printing technologies are expanding the potential applications of regenerative medicine. In 2026, companies are likely to focus more on clinical translation, scalable manufacturing, and tailored treatment approaches. The final point is an inference based on the trend discussion and forecast window on the IMARC page.
Key Growth Drivers
Increasing Prevalence of Chronic and Degenerative Disorders
IMARC states that the growing prevalence of chronic diseases and degenerative disorders is a major factor driving the United States Regenerative Medicine Market. Conditions such as cardiovascular disease, diabetes, and orthopedic ailments are increasing demand for therapies that can repair or restore damaged tissues and improve long-term outcomes.
The report also notes that rising healthcare costs associated with chronic disease management are encouraging exploration of regenerative medicine as a potentially cost-effective and curative alternative to traditional treatments. This supports stronger market interest from providers, researchers, and therapy developers heading into 2026. The last point is an inference based on IMARC’s stated market drivers.
Advancements in Stem Cell Research and Tissue Engineering
IMARC identifies ongoing advancements in stem cell research and technologies as another major growth driver. The page explains that stem cells play a central role in regenerative medicine because of their ability to differentiate into various cell types and support the regeneration of tissues and organs affected by injury, disease, or congenital disorders.
The page also states that tissue engineering, supported by biomaterials and biochemical factors, is enhancing the creation of artificial tissues and organs. In addition, continued progress in three-dimensional printing is improving the ability to create complex tissue structures, expanding the therapeutic potential of regenerative medicine.
Favorable Regulation, Precision Medicine Focus, and Collaboration
IMARC states that a supportive regulatory landscape is helping market expansion, with governing bodies such as the FDA providing clearer pathways for the development and approval of regenerative therapies. The report also notes that growing interest in precision medicine is fueling demand for tailored regenerative treatments based on individual patient characteristics.
In addition, IMARC highlights increasing awareness and acceptance of regenerative medicine, along with extensive collaborations between research institutions, biotechnology companies, and academic centers. These partnerships are fostering innovation and helping accelerate therapeutic development across multiple applications in 2026 and beyond.
United States Regenerative Medicine Market Segmentation
IMARC Group has categorized the United States Regenerative Medicine Market based on type, application, end user, and region.
By Type
• Stem Cell Therapy
• Biomaterial
• Tissue Engineering
• Others
By Application
• Bone Graft Substitutes
• Osteoarticular Diseases
• Dermatology
• Cardiovascular
• Central Nervous System
• Others
By End User
• Hospitals
• Specialty Clinics
• Others
By Region
• Northeast
• Midwest
• South
• West
Competitive Landscape
IMARC states that the report includes a comprehensive analysis of the competitive landscape, including market structure, key player positioning, top winning strategies, competitive dashboard, and company evaluation quadrant. It also notes that detailed profiles of all major companies are included in the full report.
Why This Report Matters for 2026 Buyers
For decision-makers evaluating the United States Regenerative Medicine Market, this report is useful for understanding therapy categories, application opportunities, end-user demand, and regional market coverage. It is especially relevant for 2026 planning around stem cell therapy, tissue engineering, biomaterials, and partnerships tied to precision and restorative medicine. This buyer-focused significance is an inference based on the trends, segmentation, and forecast structure shown on the IMARC page.
Questions Decision-Makers Are Asking
What is driving the United States Regenerative Medicine Market?
The market is being driven by increasing demand for innovative therapeutic solutions, advances in stem cell research, a rising geriatric population, a favorable regulatory landscape, precision medicine focus, collaborative partnerships, substantial financial support, and expanding clinical applications.
Which segments are covered in the report?
IMARC segments the market by type, application, end user, and region. These include stem cell therapy, biomaterial, tissue engineering, bone graft substitutes, osteoarticular diseases, dermatology, cardiovascular, central nervous system, hospitals, specialty clinics, and major U.S. regions.
Why is 2026 important for this market?
2026 is the first forecast year on the IMARC page and serves as a useful planning point for companies tracking therapy development, clinical adoption, regulatory progress, and commercialization opportunities. This is an inference based on the report’s forecast period and trend discussion.
Author IMARC Group
IMARC presents the study as a quantitative analysis of market segments, historical and current trends, market forecasts, and industry dynamics for the United States Regenerative Medicine Market from 2020-2034.
Contact Us
IMARC Group
US Office: +1-201-971-6302
Email: sales@imarcgroup.com
- Art
- Causes
- Crafts
- Dance
- Drinks
- Film
- Fitness
- Food
- Games
- Gardening
- Health
- Home
- Literature
- Music
- Networking
- Other
- Party
- Religion
- Shopping
- Sports
- Theater
- Wellness


